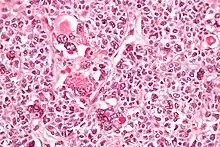

Granulosa cell tumour
| Granulosa cell tumour | |
|---|---|
| Other names | Granulosa-theca cell tumours or Folliculoma |
![]() | |
| Micrograph of a juvenile granulosa cell tumour with hyaline globules. H&E stain. | |
| Specialty | Gynecologic oncology, obstetrics and gynaecology, oncology, endocrinology |
Granulosa cell tumours are tumours that arise from granulosa cells. They are estrogen-secreting tumours and present as large, complex, ovarian masses. These tumours are part of the sex cord–gonadal stromal tumour or non-epithelial group of tumours. Although granulosa cells normally occur only in the ovary, granulosa cell tumours occur in both ovaries and testicles (see ovarian cancer and testicular cancer). These tumours should be considered malignant and treated in the same way as other malignant tumours of ovary. The ovarian disease has two forms, juvenile and adult, both characterized by indolent growth,[1] and therefore has high recovery rates.[2][3] The staging system for these tumours is the same as for epithelial tumours and most present as stage I.[4] The peak age at which they occur is 50–55 years, but they may occur at any age.
Juvenile granulosa cell tumour is a similar but histologically distinct rare tumour. It too occurs in both the ovary and testis. In the testis it is extremely rare, and has not been reported to be malignant.[5] Although this tumour usually occurs in children (hence its name), it has been reported in adults.[6]
Presentation
Estrogens are produced by functioning tumours, and the clinical presentation depends on the patient's age and sex.
- Female
- If the patient is postmenopausal, she usually presents with abnormal uterine bleeding, and in some cases hemoperitoneum.
- If the patient is of reproductive age, she would present with menometrorrhagia. However, in some cases she may stop ovulating altogether.
- If the patient has not undergone puberty, early onset of puberty may be seen.
- these tumours tend to have late recurrences (even after 30 years)
Genetics
Adult granulosa cell tumours

Using next generation DNA sequencing, 97% of adult granulosa cell tumours were found to contain an identical mutation in the FOXL2 gene . This is a somatic mutation, meaning it is not usually transmitted to descendants. Mutation c.402C>G in the sequence of FOXL2 leads to the amino acid substitution p. C134W. It is believed that this mutation may be the cause of granulosa cell tumours.
Juvenile granulosa cell tumours
Two recent studies show that the enzyme AKT1 is involved in juvenile granulosa cell tumours. In-frame duplications in the pleckstrin-homology domain of the protein were found in more than 60% of juvenile granulosa cell tumours occurring in girls under 15 years of age. The tumours without duplications carried point mutations affecting highly conserved residues. The mutated proteins carrying the duplications displayed a non-wild-type subcellular distribution, with a marked enrichment at the plasma membrane, leading to a strong activation of AKT1.[8] Analysis by RNA-Seq pinpointed a series of differentially expressed genes that are involved in cytokine and hormone signaling and cell division-related processes. Further analyses pointed to a possible dedifferentiation process, and suggested that most of the transcriptomic dysregulations might be mediated by a limited set of transcription factors perturbed by AKT1 activation. These results incriminate somatic mutations of AKT1 as probable driver events in the pathogenesis of juvenile granulosa cell tumours.[9]
Diagnosis
Gross appearance
Tumours vary in size, from tiny spots to large masses, with an average of 10 cm in diameter. Tumours are oval and soft in consistency. On cut-section, histology reveals reticular, trabecular areas with interstitial haemorrhage and Call–Exner bodies-small cyst like spaces interspersed within a Graafian follicle.
Tumour marker
Inhibin, a hormone, has been used as biomarker for granulosa cell tumours.[10]
Histology

Juvenile granulosa cell tumors can be distinguished from adult granulosa cell tumors on histology by their abundant, eosinophilic cytoplasm; primitive, highly mitotic nuclei in polygonal cells; and disorganized follicles.[12][13]
In animals
In the ovaries of aging squirrel monkeys (Saimiri sciureus), clusters of granulosa cells occur that resemble granulosa cell tumours in humans.[14] These appear to be a normal change with age in this species.
See also
- Inhibin, alpha
References
- ↑ "Prognostic factors in adult granulosa".
- ↑ Young RH, Dickersin GR, Scully RE (1984). "Juvenile granulosa cell tumor of the ovary. A clinic pathological analysis of 125 cases. Beth Israel Deaconess Medical Center, Boston". American Journal of Surgical Pathology. 8 (8): 575–596. doi:10.1097/00000478-198408000-00002. PMID 6465418. S2CID 25845267.
- ↑ "Program in Gynecologic Medical Oncology, Beth Israel Deaconess Medical Center, Boston".
- ↑ Gynaecology. 3rd Ed. 2003. Churchill Livingstone, pp. 690-691.
- ↑ Dudani R, Giordano L, Sultania P, Jha K, Florens A, Joseph T (April 2008). "Juvenile granulosa cell tumor of testis: case report and review of literature". American Journal of Perinatology. 25 (4): 229–231. doi:10.1055/s-2008-1066878. PMID 18548396.
- ↑ Lin KH, Lin SE, Lee LM (July 2008). "Juvenile granulosa cell tumor of adult testis: a case report". Urology. 72 (1): 230.e11–3. doi:10.1016/j.urology.2007.11.126. PMID 18313118.
- ↑ - Vaidya, SA; Kc, S; Sharma, P; Vaidya, S (2014). "Spectrum of ovarian tumors in a referral hospital in Nepal". Journal of Pathology of Nepal. 4 (7): 539–543. doi:10.3126/jpn.v4i7.10295. ISSN 2091-0908.
- Minor adjustment for mature cystic teratomas (0.17 to 2% risk of ovarian cancer): Mandal, Shramana; Badhe, Bhawana A. (2012). "Malignant Transformation in a Mature Teratoma with Metastatic Deposits in the Omentum: A Case Report". Case Reports in Pathology. 2012: 1–3. doi:10.1155/2012/568062. ISSN 2090-6781. PMC 3469088. PMID 23082264. - ↑ Bessière L, Todeschini AL, Auguste A, Sarnacki S, Flatters D, Legois B, Sultan C, Kalfa N, Galmiche L, Veitia RA (March 2015). "A Hot-spot of In-frame Duplications Activates the Oncoprotein AKT1 in Juvenile Granulosa Cell Tumors". eBioMedicine. 2 (5): 421–431. doi:10.1016/j.ebiom.2015.03.002. PMC 4485906. PMID 26137586.
- ↑ Auguste A, Bessière L, Todeschini AL, Caburet S, Sarnacki S, Prat J, D'angelo E, De La Grange P, Ariste O, Lemoine F, Legois B, Sultan C, Zider A, Galmiche L, Kalfa N, Veitia RA (Dec 2015). "Molecular analyses of juvenile granulosa cell tumors bearing AKT1 mutations provide insights into tumor biology and therapeutic leads". Human Molecular Genetics. 24 (23): 6687–6698. doi:10.1093/hmg/ddv373. PMID 26362254.
- ↑ Richard E. Lappöhn; Henry G. Burger; Joke Bouma; Mohan Bangah; Mindert Krans; Henk W.A. De Bruijn (September 21, 1989). "Inhibin as a Marker for Granulosa-Cell Tumors". N Engl J Med. 321 (12): 790–793. doi:10.1056/NEJM198909213211204.
- ↑ Schubert TE, Stoehr R, Hartmann A, Schöne S, Löbelenz M, Mikuz G (2014). "Adult type granulosa cell tumor of the testis with a heterologous sarcomatous component: case report and review of the literature". Diagn Pathol. 9: 107. doi:10.1186/1746-1596-9-107. PMC 4100032. PMID 24894598.
{{cite journal}}: CS1 maint: multiple names: authors list (link) - Figure 2
- "This article is licensed under a Creative Commons Attribution 4.0 International License" - ↑ Zuckerman, Andrea L.; Pourvaziri, Ali; Ebb, David H.; Boyraz, Baris (2023-08-24). Cabot, Richard C.; Rosenberg, Eric S.; Dudzinski, David M.; Baggett, Meridale V.; Tran, Kathy M.; Sgroi, Dennis C.; Shepard, Jo-Anne O.; McDonald, Emily K.; Corpuz, Tara (eds.). "Case 26-2023: A 15-Year-Old Girl with Abdominal Pain and an Ovarian Mass". New England Journal of Medicine. 389 (8): 750–758. doi:10.1056/NEJMcpc2211422. ISSN 0028-4793.
- ↑ Young, R. H.; Dickersin, G. R.; Scully, R. E. (August 1984). "Juvenile granulosa cell tumor of the ovary. A clinicopathological analysis of 125 cases". The American Journal of Surgical Pathology. 8 (8): 575–596. doi:10.1097/00000478-198408000-00002. ISSN 0147-5185. PMID 6465418.
- ↑ Walker ML, Anderson DC, Herndon JG, Walker LC (2009). "Ovarian aging in squirrel monkeys (Saimiri sciureus)". Reproduction. 138 (4): 793–799. doi:10.1530/REP-08-0449. PMC 7723027. PMID 19656956.